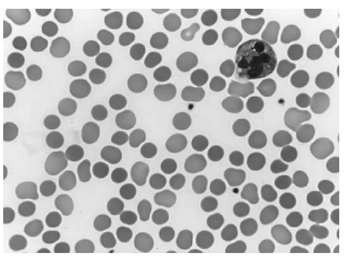
Enunciado 4925828-1

Foram encontradas 100 questões.
Uma paciente de 54 anos de idade em amenorreia há 1
ano referiu calores corporais tipo fogachos, irritabilidade
e insônia. Há 8 anos, foi submetida à histerectomia por
mioma uterino e, no momento, não faz uso de nenhuma
medicação. A paciente apresenta mamografia e exames
laboratoriais normais. O ginecologista indicou terapia
hormonal do climatério.
Com base nesse caso clínico hipotético, é correto afirmar que
Com base nesse caso clínico hipotético, é correto afirmar que
Provas
Questão presente nas seguintes provas
Uma forma eficaz de prevenção do câncer de colo uterino e
das verrugas genitais é a vacina contra o HPV. Em relação a
essa medida, é correto afirmar que
Provas
Questão presente nas seguintes provas
Paciente de 45 anos de idade, com exame ginecológico
normal e assintomática, foi submetida à mamografia de
rotina. O laudo concluiu como resultado BI-RADS 3.
Com base nesse caso clínico hipotético, assinale a opção correta a respeito da conduta a ser seguida.
Com base nesse caso clínico hipotético, assinale a opção correta a respeito da conduta a ser seguida.
Provas
Questão presente nas seguintes provas
A endometriose pélvica afeta cerca de 10 a 12% de mulheres
em idade reprodutiva, podendo causar infertilidade e dor
pélvica. Em relação a essa afecção, é correto afirmar que
Provas
Questão presente nas seguintes provas
Uma paciente de 60 anos de idade, com menopausa
aos 48, referiu sangramento genital em pequena
quantidade sem cólicas por 4 dias, e que findou há 20 dias
espontaneamente. O exame ginecológico foi normal e a
ultrassonografia transvaginal revelou útero com 56 cc de
volume, mioma intramural de 1 cm e eco endometrial de
3 mm. Referiu ter diabetes tipo 2 e hipertensão arterial com
uso de metformina e enalapril. A causa do sangramento é
Provas
Questão presente nas seguintes provas
Uma paciente com 16 anos de idade, em amenorreia
primária, foi diagnosticada com síndrome de Turner, na
forma não mosaico.
Com base nesse caso clínico hipotético, em relação a esse diagnóstico, é correto afirmar que
Com base nesse caso clínico hipotético, em relação a esse diagnóstico, é correto afirmar que
Provas
Questão presente nas seguintes provas
Paciente feminina, 35 anos de idade, obesa (IMC 34 kg/m²),
internada no primeiro dia por colecistite aguda, apresentou
clearance de creatinina estimado 28 mL/min/1,73 m².
Referiu histórico de trombose venosa profunda já há 5
anos, ocorrida após uma viagem internacional de avião,
que foi tratada com anticoagulação por seis meses
sem recidiva.
Com base nesse caso clínico hipotético e considerando o perfil de risco para TEV, assinale a opção que apresenta a conduta adequada para a profilaxia de TEV.
Com base nesse caso clínico hipotético e considerando o perfil de risco para TEV, assinale a opção que apresenta a conduta adequada para a profilaxia de TEV.
Provas
Questão presente nas seguintes provas
Paciente masculino, 42 anos de idade, asmático grave,
apresentou crise de asma refratária apesar de nebulização
com β2-agonista de alta dose, corticosteroides intravenosos
e oxigenoterapia. Referiu histórico de insuficiência cardíaca
crônica com fração de ejeção 35%. Estava taquipneico,
com uso intenso de musculatura acessória, saturação
88% em oxigênio suplementar e apresentava hipercapnia
progressiva na gasometria arterial. Equipe de emergência
decidiu realizar intubação orotraqueal de sequência
rápida devido à falha da terapia medicamentosa e ao risco
iminente de fadiga respiratória.
Com base nesse caso clínico hipotético e considerando sedação e indução para intubação, assinale a opção que apresenta maior potência broncodilatadora e perfil mais seguro para esse paciente.
Com base nesse caso clínico hipotético e considerando sedação e indução para intubação, assinale a opção que apresenta maior potência broncodilatadora e perfil mais seguro para esse paciente.
Provas
Questão presente nas seguintes provas
- Psicofarmacologia
- Transtornos MentaisAnsiedade, Dissociativos e SomatoformesAnsiedade, Fobias e Síndrome do Pânico
Mulher de 26 anos de idade, saudável, sem uso prévio de
medicações, procurou atendimento por crises frequentes
de ansiedade generalizada há vários meses, com sintomas
diários de preocupação excessiva, insônia, irritabilidade,
tensão muscular e dificuldade de concentração. Relatou
episódios atuais, frequentes e intensos de ansiedade, com
palpitações, sudorese e sensação de falta de controle,
que a impedem de realizar atividades acadêmicas e
sociais. Após avaliação psiquiátrica, foi indicado início de
tratamento farmacológico.
Com base nesse caso clínico hipotético, assinale a opção que apresenta a conduta farmacológica mais adequada para essa paciente.
Com base nesse caso clínico hipotético, assinale a opção que apresenta a conduta farmacológica mais adequada para essa paciente.
Provas
Questão presente nas seguintes provas
Paciente homem de 32 anos de idade apresentou anemia
grave (Hb 7,2 g/dl), reticulocitose, icterícia, esplenomegalia
e história familiar de anemia. Laboratorialmente
apresentava os seguintes resultados: VCM 90 fL; LDH
elevado; bilirrubina indireta aumentada; haptoglobina
indetectável; teste de Coombs negativo; esfregaço de
sangue periférico abaixo.

Com base nesse caso clínico hipotético, assinale a opção que apresenta o provável diagnostico.
Com base nesse caso clínico hipotético, assinale a opção que apresenta o provável diagnostico.
Provas
Questão presente nas seguintes provas
Cadernos
Caderno Container